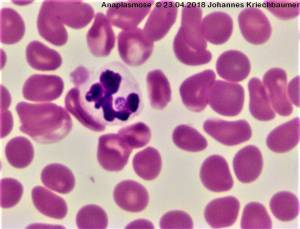
zytologie_-_anaplasmose_johannes_kriechbaumer_2018_.jpg zytologie_-_anaplasmose_johannes_kriechbaumer_2018_.jpg

anaplasmose
Inhaltsverzeichnis
Anaplasmose
Ursache
- Anaplsamen: gram-neg. Bakterien, Rickettsien
- Inkubationszeit 4-7 Tage
- Bakteriämie ca 4 Wochen
- A. phagozytophilum –> canine granulozytäre Anaplasmose
- Überträger: Ixodes ricinus (muss 36-48 Std. am Writ anhaften für Übertragung)
- infiziert neutrophiele Granulozyten –> vom Blut aus Infektion Leber, Lunge, ZNS, Nieren, …
- endemisch in DE
- verschiedene genetische Varianten - dadurch wahrscheinlich unterschiedliche Pathogenität
- meist lebenslange Infektion (auch nicht mit Therapie)
- A. platys –> canine zyklische Thrombozytopenie
- Überträger: braune Hundezecke
- nicht endemisch in DE - eher nach Aufenthalt in mediterranen Regionen
- häufige Infektion - selten Symptome
- jeder dritte bis fünfte Hund hatte in DE AK gegen A. phagozytophilum und nur 1% gegen E. canis
Symptome
- meist asymptomatische / selbstlimitierend
- Symptome nur während der akuten Phase (Bakteriämie)
- Fieber häufig
- Thrombozytopenie: petechiale Blutungen, Epistaxis
- Lethargie
- Polyarthritis: akute Lahmheit, häufig Karpalgelenke betroffen
- Meningitis: neurologische Ausfälle, Krämpfe, Halsbiegeschmerz
- Gewichtsverlust
- Ödeme an den Gliedmaßen
- Lymphadenopathie
Diagnose
- für Diagnosestellung müssen 3 Befunde vorliegen
- positiver direkter Erregernachweis: Morulae in Blutausstrich / PCR
- Thrombozytopenie
- Besserung der Thrombozytopenie unter Doxycyclin in wenigen Tagen
- Blut
- Thrombozytopenie (80%)
- nicht reg. Anämie (50%)
- Lymphopenie (90%)
- ALB↓ (90%).
- Zytologie
- Material: Kapillarblut (EDTA), FNA Milz, Lnn., Knochenmark
- Erreger in den Neutros erst wenn Morula-Stadium erreicht ist nachweisbar (keine Unterscheidung zw. Anaplasmen und Ehrlichien)
- es müssen nicht zwingend sichtbare intragranulozytäre Morulae vorhanden sein - nur im positiven Fall beweisend
- PCR: AG auf A. spp.
- positiv 6-8 Tage vor und 3 Tage nach Auftreten v. Morulae
- andere Quelle: experimentell Infizierte Tiera ab 2 Tage nach Infektion bis 20-60 Tage nach Infektion positiv
- AK-Serologie
- Zyto aus Knochenmark, Blut, Leber, Milz (Erreger sind in Neutros), 4Dx
- Titer frühestens >7 Tage nach Infekt positiv: bei akuten Krankheitssymptomen meist noch nicht nachweisbar (nicht geeignet zum Nachweis einer akuten klinisch manifesten Anaplasmose
- keine Aussage über klinische Manifestation
Therapie & Prognose
- Therapie nur bei Hunden mit Symptomen
- Doxycyklin 5-10 mg/kg bid für 3-4 Wo
- Kontrolle in 2-3 Tage
- die meisten Tiere sprechen schnell an –> Anstieg der Thrombos
- Kontrolle: nach erfolgreicher Tx dauert es 7-8 Mo bis keine AK mehr im Blut nachweisbar waren
- Prognose gut
Prophylaxe
- keine Impfung gegen A. phagozytophilum in DE
- Zeckenprophylaxe mit repelliereden Mitteln
Quellen
- Bergmann M, Hartmann K (2015): Anaplasmose beim Hund - Infektion häufig, Krankheit selten. Kleintier Konkret 5: 3-7.
anaplasmose.txt · Zuletzt geändert: 2020/11/10 09:46 von m2